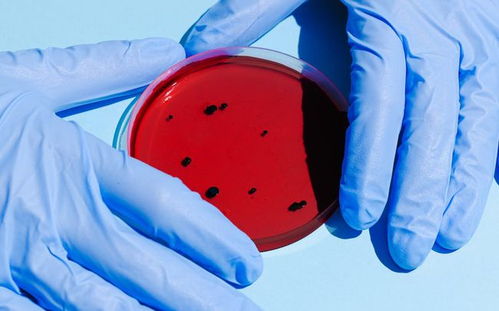
傳染病標(biāo)本采集注意事項(xiàng),春季傳染病注意事項(xiàng),冬季傳染病注意事項(xiàng)

留取標(biāo)本時(shí)應(yīng)注意: (1) 傷寒:①血培養(yǎng)是本病最常用的確診依據(jù),發(fā)病第1?2周血培養(yǎng)陽性率最高。
②骨髓培養(yǎng)陽性率高于血培養(yǎng),持續(xù)時(shí)間長,對已用抗生素治療的病人尤為適用。③糞便培 養(yǎng)在發(fā)病3?4周陽性率最高,病人排便后,可挑取含膿、血或黏液部分的糞便2?3g,液體 糞便取絮狀物及時(shí)送檢。
④十二指腸膽汁引流培養(yǎng)適用于慢性帶菌者。⑤玫瑰疹吸取物培 養(yǎng)亦可獲傷寒沙門菌。
(2) 細(xì)菌性食物中毒:對可疑食物、病人嘔吐物、糞便等做細(xì)菌培養(yǎng)。 (3) 細(xì)菌性痢疾:發(fā)病早期、連續(xù)多次、抗菌治療前、采新鮮糞便的膿血部分培養(yǎng),同時(shí) 可做藥物敏感試驗(yàn)。
(4) 霍亂:采集病人新鮮糞便含膿、血或黏液部分2?3g,液體糞便取絮狀物及時(shí)送檢。 (5) 阿米巴痢疾:①由于在黏液部分較血性部分易于發(fā)現(xiàn)滋養(yǎng)體,且阿米巴滋養(yǎng)體排 出體外2小時(shí)即趨于死亡,因而,宜采取新鮮膿血便送檢,以提高陽性率。
②留取標(biāo)本的容 器應(yīng)清潔,不混有尿液及消毒液。 氣溫低時(shí),便盆應(yīng)先用溫水沖洗,送標(biāo)本的容器應(yīng)設(shè)法保 持一定的溫度并立即送檢。
③若有服用油類、鉍劑及鋇劑者,應(yīng)在停服以上藥物3天以后留 取糞便標(biāo)本送檢。 (6) 甲型肝炎:①血清抗HAV-IgM是HAV近期感染的指標(biāo),是確診甲型肝炎最主要的標(biāo) 記物。
②血清抗HAV-IgG為保護(hù)性抗體見于甲型肝炎疫苗接種后或既往感染HAV的病人。 (7) 戊型肝炎抗HEV-IgM及抗HEV-IgG作為近期感染指標(biāo)。
標(biāo)本不能正確采集就不能準(zhǔn)確找到病原微生物,甚至將分離 到的正常菌群或污染微生物當(dāng)作病原微生物,貽誤診斷和治療。
為了準(zhǔn)確找到病原微生物,采集標(biāo)本時(shí)應(yīng)注意以下幾點(diǎn):送培養(yǎng)的標(biāo)本必須準(zhǔn)確地從感染部位采集,盡可能避免 污染,例如未經(jīng)指導(dǎo)采集的痰中常摻和了唾液,培養(yǎng)后可見很多 口腔污染菌,而肺部感染的致病菌卻不生長。盡可能在合適的時(shí)間采集標(biāo)本,例如清晨的痰和尿液的 含菌量較多,是采集的最佳時(shí)間。
了解傳染病的自然過程有助于 決定采集何種標(biāo)本及其采集時(shí)間。必要的免疫學(xué)知識(shí)對解釋血清學(xué)試驗(yàn)結(jié)果十分有用。
應(yīng)盡量采集足夠的標(biāo)本送實(shí)驗(yàn)室,如成人的血培養(yǎng)標(biāo)本 每次采集10ml或更多。使用合適器械和運(yùn)送容器很重要,所有標(biāo)本都應(yīng)使用無 菌容器。
棉拭子常與運(yùn)送培養(yǎng)基配合應(yīng)用,但棉拭子不宜做厭氧 菌培養(yǎng)。任何送厭氧培養(yǎng)的標(biāo)本應(yīng)做到在厭氧環(huán)境下運(yùn)送。

您好,肺結(jié)核是通過飛沫傳染,兩個(gè)人在2米內(nèi)這個(gè)距離內(nèi)有傳染的可能性,肺結(jié)核桿菌具有很強(qiáng)的傳染性,且有耐藥性和變異性,隔離防護(hù)是肺結(jié)核治療和護(hù)理的重要措施。
矽肺病還伴有開放性肺結(jié)核的患者,是應(yīng)該積極治療的,請盡快讓他入院治療為好。 矽肺(silicosis)是由于長期吸入游離二氧化矽粉塵所致的以肺部彌漫性纖維化為主的全身性疾病,粉塵中游離二氧化矽含量的多少,生產(chǎn)環(huán)境中粉塵濃度的高低以及生產(chǎn)者暴露時(shí)間的長短是矽肺病發(fā)生、發(fā)展及轉(zhuǎn)歸的主要影響因素。
其臨床表現(xiàn)為:胸悶、胸痛、咳嗽。 1、經(jīng)常開窗通風(fēng),保持室內(nèi)空氣新鮮。
2、及時(shí)消除呼吸道痰液,每日飲水量1000-2000ml,以利痰咳出。 3、氧療,每日達(dá)15小時(shí)以上。
4、預(yù)防上呼吸道感染,進(jìn)行耐寒鍛煉。 5、進(jìn)行呼吸功能鍛煉,進(jìn)行腹式呼吸縮唇呼吸,作呼吸操。
6、合理飲食、進(jìn)食高蛋白、營養(yǎng)豐富的飲食,多吃蔬菜水果,促進(jìn)食欲,增強(qiáng)機(jī)體抵抗力。 “肺結(jié)核”是一種由結(jié)核分支桿菌所引起的慢性呼吸道傳染病。
分原發(fā)型、浸潤型、粟粘型、慢性纖維少洞型和結(jié)核性胸膜炎五大類。以青少年居多。
典型癥狀包括全身中毒癥狀,如發(fā)熱、盜汗、疲乏、消瘦、納差、月經(jīng)失調(diào)等,呼吸道局部癥狀有咳嗽、咯痰和咯血、腸病、氣促等。 大多起病緩慢,病情較輕者,有的無自覺癥狀,需X線 檢查才發(fā)現(xiàn)。
多數(shù)病人及時(shí)發(fā)現(xiàn)后,經(jīng)過積極治療和休養(yǎng),可恢復(fù)健康,如不及時(shí)治療,可發(fā)生組織破壞而形成空洞。 護(hù)理要點(diǎn) ◆ 做好家庭消毒隔離。
最好讓病人獨(dú)居一室,選擇朝陽或通風(fēng)條件好的房間。 室內(nèi)不能潮濕。
病人的寢具、食具獨(dú)用,并定期消毒。痰液最好吐在紙內(nèi),然后燒毀,切忌隨地吐痰。
病人不宜與兒童接觸,盡量不到公共場所去,以免病菌擴(kuò)散傳染,影響他人健康??人院蛧娞鐣r(shí),用手帕捂住口鼻。
被褥經(jīng)常放在太陽下曝曬,餐具可作煮沸消毒。 ◆ 病人發(fā)生少量咯血時(shí),護(hù)理者首先要穩(wěn)定他的情緒,因過度緊張、激動(dòng)會(huì)增加咯血量,過分害怕咯血、拼命屏氣則容易引起窒息。
應(yīng)讓病人靜臥,用冷毛巾敷額部或胸部。也可以吃一些冷飲以幫助止血。
咯血?jiǎng)偼?,不宜立即起床活?dòng)。 ◆ 肺結(jié)核病人往往胃納較差,飲食宜清淡,易消化,注意適當(dāng)補(bǔ)充蛋白質(zhì)和維生素類。
疾病好轉(zhuǎn)時(shí)期,病人食欲改善,則要多吃一些瘦肉、魚類、蛋品、豆制品和新鮮蔬菜。 飲食要有規(guī)律,選擇上不能偏食,以保證各種營養(yǎng) 成分的攝入。
病人應(yīng)戒煙忌酒。 ◆ 病人如突然大量咯血或咯血突然停止,并伴有胸悶、氣急、煩躁、出冷汗,甚至面色發(fā)紫,這是窒息的預(yù)兆,應(yīng)立即讓病人側(cè)臥,鼓勵(lì)和幫助病人將血塊咯出,并立即將病人送醫(yī)院搶救。
還有他的食物禁忌:結(jié)核病人特別是服異煙肼、利福平等抗結(jié)核藥物時(shí),常會(huì)引起食物中毒或食物過敏,常見的有:茄子,牛奶,某些魚類-能引起過敏的魚類一般為無鱗類和不新鮮的海魚、淡水魚。 補(bǔ)充,抱歉,忽略了非開放性和開放性肺結(jié)核了,開放性肺結(jié)核是指痰?群薪岷司崠è靖?e人的病人,這種開放性病人比較少,約占全部肺結(jié)核病人的 10% 。
非開放性肺結(jié)核是指痰?炔緩岷司換崠è靖?e人的病人,這種非開放性病人比較多,約占全部肺結(jié)核病人的 90% 。所以肺結(jié)核病人大部分是不會(huì)傳染?e人的,會(huì)傳染給?e人的只有少部分的病人。
但開放性病人與非開放性病人具有互動(dòng)關(guān)系,開放性病人給予有效治療后,可以變成非開放性病人;相反,非開放性病人不接受治療或者治療不適當(dāng),也會(huì)變成開放性病人。 肺結(jié)核的主要傳播途徑是飛沫傳染。
開放性肺結(jié)核病人在咳嗽、噴嚏、大聲談笑時(shí)噴射出帶菌的飛沫而傳染給健康人。病人如隨地吐痰,待痰液干燥后痰菌隨灰塵在空氣中飛播而傳染。
凡痰中找到結(jié)核桿菌的病人外出應(yīng)戴口罩,不要對著別人面部講話,不可隨地吐痰,應(yīng)吐在手帕或廢紙內(nèi),集中消毒或用火焚燒滅菌。 痰液可用5~12%的來蘇溶液浸泡2~12小時(shí)消毒。
病人應(yīng)養(yǎng)成分食制習(xí)慣,與病人共餐或食入被結(jié)核桿菌污染的食物可引起消化道感染。 使用的被褥等物品要經(jīng)常放在陽光下曝曬。
要按醫(yī)囑定時(shí)不間斷地服藥,這是消除傳染的重要前提。 非開放性肺結(jié)核痰內(nèi)一般不含結(jié)核菌,傳染性沒有或較低,除非抵抗力較差有慢性疾病等。
只要對治療中的開放性肺結(jié)核的病人,以上護(hù)理事項(xiàng)能堅(jiān)持嚴(yán)格做到,那么就不會(huì)把病傳染給你們,如果當(dāng)著他面戴著口罩同樣也是很別扭的,所以不必的。如治療結(jié)束,病已痊愈,傳染性也沒有了,所以不必?fù)?dān)心,多給他一些關(guān)懷,好好招待他,:)。
以上供您參考,祝安康。
標(biāo)本的采集非常重要。
細(xì)菌感染通常是通過培養(yǎng)的方法檢測的,而病毒通常是通過抗原或者核酸來檢測的。細(xì)菌培養(yǎng)和鑒定,以及藥敏試驗(yàn),是合理使用抗菌藥物的前提,好的標(biāo)本決定一切,這是檢驗(yàn)領(lǐng)域的一句俗話。
不恰當(dāng)?shù)臉?biāo)本、不恰當(dāng)?shù)牟杉瘯r(shí)間、不規(guī)范的采集方法,很可能造成假陰性,假陽性,雜菌污染等,延誤診斷,危及生命。對于嚴(yán)重感染,我們是需要確定病原菌的,標(biāo)本應(yīng)該選擇細(xì)菌可能定植的部位,如深部痰液,胸水,血液等,標(biāo)本提取的時(shí)間應(yīng)該在抗菌藥物使用前,最好在發(fā)生寒戰(zhàn)的時(shí)候。
標(biāo)本的采集一定要規(guī)范,避免把護(hù)士或醫(yī)生手上,導(dǎo)管,或者采集器本身的雜菌帶入標(biāo)本。病毒感染較少檢測,除了一些特殊的,如肝炎病毒,巨細(xì)胞病毒,以及其他一些傳染病病毒等。
病毒要達(dá)到一定拷貝量,才能用核酸定量的方法檢測出來。而抗原抗體檢測,相對來水受到標(biāo)本影響較小。
標(biāo)本的采集非常重要。
細(xì)菌感染通常是通過培養(yǎng)的方法檢測的,而病毒通常是通過抗原或者核酸來檢測的。
細(xì)菌培養(yǎng)和鑒定,以及藥敏試驗(yàn),是合理使用抗菌藥物的前提,好的標(biāo)本決定一切,這是檢驗(yàn)領(lǐng)域的一句俗話。不恰當(dāng)?shù)臉?biāo)本、不恰當(dāng)?shù)牟杉瘯r(shí)間、不規(guī)范的采集方法,很可能造成假陰性,假陽性,雜菌污染等,延誤診斷,危及生命。
對于嚴(yán)重感染,我們是需要確定病原菌的,標(biāo)本應(yīng)該選擇細(xì)菌可能定植的部位,如深部痰液,胸水,血液等,標(biāo)本提取的時(shí)間應(yīng)該在抗菌藥物使用前,最好在發(fā)生寒戰(zhàn)的時(shí)候。標(biāo)本的采集一定要規(guī)范,避免把護(hù)士或醫(yī)生手上,導(dǎo)管,或者采集器本身的雜菌帶入標(biāo)本。
病毒感染較少檢測,除了一些特殊的,如肝炎病毒,巨細(xì)胞病毒,以及其他一些傳染病病毒等。病毒要達(dá)到一定拷貝量,才能用核酸定量的方法檢測出來。而抗原抗體檢測,相對來水受到標(biāo)本影響較小。
小兒傳染病的預(yù)防和護(hù)理 (同樣適合于成人) 小兒傳染病的基本情況 小兒傳染病是由于病原體(細(xì)菌、病毒或病原蟲)引發(fā)的疾病。
雖然某些疾病成人也可患上,但人數(shù)很少,并且癥狀很重,易出現(xiàn)并發(fā)癥,與孩子患病有所不同。小兒傳染病的種類很多,主要分為細(xì)菌性感染和病毒性感染兩大類。
其中主要包括水痘、流行性腮腺炎、幼兒急疹、天花、白喉、脊髓灰質(zhì)炎、百日咳、破傷風(fēng)、猩紅熱等。 傳染途徑 小兒傳染病的傳染途徑主要分為呼吸道傳染和消化道傳染兩種。
呼吸道傳染病是患兒在說話、呼吸、打噴嚏、咳嗽時(shí)將病原體播散在空氣中,被健康孩子通過口、鼻吸入體內(nèi)而感染發(fā)病。如白喉、百日咳、肺結(jié)核、猩紅熱等就是典型的病例。
消化道傳染病是健康的孩子誤服了被污染的食物或水,或用手摸了被污染的玩具后,又吮手指或不洗手就吃東西,造成病原體由口進(jìn)入體內(nèi)。如痢疾、脊髓灰質(zhì)炎(小兒麻痹)、肝炎等就是典型的病例。
另外,小兒傳染病還有一種傳染途徑,即通過傷口感染,如破傷風(fēng)。 預(yù)防和護(hù)理 現(xiàn)在已經(jīng)有了很多預(yù)防接種的方法,但并不是對所有傳染病都能奏效。
有的病即使能夠預(yù)防接種,也不能百分之百達(dá)到預(yù)防的目的。因此還要加強(qiáng)對孩子的護(hù)理,這也是預(yù)防感染的一個(gè)重要途徑。
第一, 要講衛(wèi)生,切斷傳染源。許多傳染病是由口、鼻而入,通過呼吸道及消化道傳染的。
因此,保持良好的衛(wèi)生習(xí)慣對于每個(gè)孩子都是十分重要的。比如不喝生水,不隨地大小便,不吮手指,飯前、便后洗手等,這些都是切斷傳染源的重要手段。
第二, 發(fā)現(xiàn)孩子得了傳染病要迅速隔離,切斷傳染途徑。接觸過病原的孩子也要另外隔離、檢疫,必要時(shí)可給予一些預(yù)防的藥物口服,如中藥“板藍(lán)根沖劑”。
另外,可以給已經(jīng)有傳染病發(fā)生的幼兒園的孩子,開一些預(yù)防的中藥煎劑吃,可以起到好的效果。 第三, 有條件的話,在接觸了傳染病病原,但未出現(xiàn)癥狀時(shí),可以通過人血球蛋白肌肉注射,來提高肌體抵抗力。
第四, 由于傳染病一般有1~2周的潛伏期,因此,在傳染病流行的時(shí)期,若懷疑孩子與病原有接觸時(shí),就要求父母細(xì)心觀察,一旦發(fā)現(xiàn)孩子有異常癥狀,如發(fā)熱、吃飯不好、不愛玩等,就應(yīng)盡早隔離,及早就醫(yī)。 小兒傳染病的潛伏期 小兒傳染病的潛伏期的長短要看是哪種傳染病而定。
根據(jù)潛伏期,通過了解患有某種傳染病的孩子得了幾天病,就可以計(jì)算出患病的孩子有沒有傳染性,由此可以得出自己的孩子被傳染的幾率到底有多大。 總的來說,小兒傳染病的潛伏期基本限定在3周以內(nèi)。
潛伏期內(nèi)的孩子,當(dāng)癥狀不明顯或無癥狀時(shí),特別容易將病原體傳染給其他孩子。冬春季節(jié)是孩子傳染病的多發(fā)季節(jié),在此期間應(yīng)加強(qiáng)對孩子的護(hù)理,適時(shí)更衣,饑飽適度,少去公共場所,以減少孩子傳染病的發(fā)生。
如果發(fā)現(xiàn)孩子出現(xiàn)傳染病的先兆癥狀時(shí),應(yīng)迅速診治,及時(shí)隔離。 小兒傳染病的隔離時(shí)間 小兒傳染病的隔離時(shí)間平均為1~2周,但具體到某種傳染病,隔離的時(shí)間則長短不一。
麻疹病人的隔離時(shí)間一般為出疹子后1周。如果并發(fā)肺炎,則應(yīng)將隔離時(shí)間延長到出疹子后的10天。
風(fēng)疹病人在皮疹出現(xiàn)后的第5天,其傳染性即消失,這時(shí)就可以不用隔離了。但妊娠婦女應(yīng)與風(fēng)疹病人嚴(yán)格隔離,因妊娠3個(gè)月內(nèi)患風(fēng)疹最容易導(dǎo)致胎兒畸形。
如果已經(jīng)因患風(fēng)疹生過畸形孩子,下一胎就應(yīng)相隔3年以上,以免再次出現(xiàn)畸形。 幼兒急疹一般在孩子半歲左右時(shí)發(fā)生,沒有和其他孩子接觸的,一般可不隔離。
如果在托兒所中發(fā)現(xiàn)了患幼兒急疹的孩子,應(yīng)對與之接觸的孩子嚴(yán)密觀察10天左右。這時(shí)如果有孩子出現(xiàn)高熱,應(yīng)馬上隔離。
水痘患兒一般應(yīng)隔離到皮疹結(jié)痂變干,痂落為止。在托兒所、幼兒園以及病房內(nèi)應(yīng)加強(qiáng)隔離。
患流行性腮腺炎的孩子應(yīng)隔離到腮腺腫大完全消退為止,大約需2周左右的時(shí)間。 患猩紅熱的孩子在咽拭子培養(yǎng)3次陰性后,方能解除隔離。
隔離時(shí)間一般為疹退后2周。 得了傳染病的孩子要隔離,主要是為了不讓傳染病病原體再傳染給其他孩子,即不讓傳染病再繼續(xù)流行開,同時(shí)也可以讓患病的孩子得到更好的休息。
在醫(yī)院如何避免交叉感染 孩子在醫(yī)院看病時(shí)可能被傳染上其他的病,這不是每個(gè)父母都能想到的,即使知道也不太了解是怎么被傳染的。這里就簡單介紹一下如何避免交叉感染。
第一,教育孩子到醫(yī)院后不要亂摸亂動(dòng)。醫(yī)院的桌椅、地面經(jīng)過各種病人的摸踩,必然會(huì)存有大量的細(xì)菌、病毒或其他病原體。
如果孩子到醫(yī)院亂摸、亂動(dòng),可能就會(huì)被傳染上這些病菌而引起相應(yīng)的疾病。 第二,在醫(yī)院內(nèi)不要吃東西。
有很多父母怕小孩就診時(shí)哭鬧,就給小孩買一些飲料與食品。這樣一來,在孩子吃東西時(shí),臟手把病原體一起吃進(jìn)口中,增加了孩子被傳染的可能性。
第三,帶孩子到醫(yī)院看病的時(shí)間要盡可能短些。因?yàn)獒t(yī)院里的空氣不干凈,特別是流行病多發(fā)季節(jié)更是如此。
孩子機(jī)體抵抗力弱,很容易感染疾病。因此,一般在孩子看完病后,應(yīng)由父母中的一位帶孩子迅速離開醫(yī)院,另一位則留在醫(yī)院繼續(xù)給孩子劃價(jià)、取藥,這樣可以減少孩子在醫(yī)院停留的時(shí)間。
第四,帶孩子先到兒科分診臺(tái)(兒科服務(wù)臺(tái)、初檢臺(tái))。在兒科分診臺(tái)進(jìn)行初步檢。

聲明:本網(wǎng)站尊重并保護(hù)知識(shí)產(chǎn)權(quán),根據(jù)《信息網(wǎng)絡(luò)傳播權(quán)保護(hù)條例》,如果我們轉(zhuǎn)載的作品侵犯了您的權(quán)利,請?jiān)谝粋€(gè)月內(nèi)通知我們,我們會(huì)及時(shí)刪除。
蜀ICP備2020033479號(hào)-4 Copyright ? 2016 學(xué)習(xí)鳥. 頁面生成時(shí)間:4.044秒